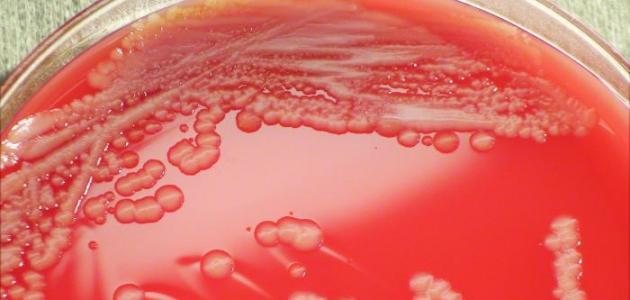

محتويات

تنتج بكتيريا الدم (بالإنجليزيّة: Septicemia) في الغالب بسبب الإصابة بعدوى بكتيريّة، حيث تُعَدُّ الالتهابات البكتيريّة هي المُسبِّب الأوَّل للإصابة ببكتيريا الدم، إلا أنَّه من الممكن أيضاً للعدوى الفيروسيّة أن تتسبَّب بحدوثها، وهناك العديد من الأسباب والمشاكل الصحِّية التي قد تكون السبب في انتشار العدوى في الدم، مثل:[١]
- التهاب السحايا.
- التهاب الزائدة الدوديّة.
- التهاب المسالك البوليّة.
- الالتهاب الرئويّ.
تظهر بعض الأعراض المُبكِّرة على المصاب ببكتيريا الدم، ومنها ما يأتي:[٢]
- التنفُّس السريع، والمعاناة من ضيق التنفُّس.
- زيادة إفراز الجلد للعرق.
- زيادة مُعدَّل ضربات القلب.
- تغيُّر الحالة الذهنيّة، مثل: الارتباك، أو الشعور بالنعاس، أو فقدان الاهتمام.
- ارتفاع درجة حرارة الجسم، أو الشعور بالبرد، أو القشعريرة.
وفي حال عدم تلقِّي العناية الطبِّية عند ظهور هذه الأعراض فإنَّ الحالة تتطوَّر إلى حدوث الصدمة الإنتانيّة (بالإنجليزيّة: septic Shock)، وتتضمَّن أعراضها ما يأتي:[٢]
- التقيُّؤ، أو الشعور بالغثيان.
- فقدان الوعي.
- فقدان التركيز، أو الشعور بالارتباك.
- صعوبة التنفُّس.
- الإسهال.
- التبوُّل بكمِّيات قليلة.
- الشعور بالدوار، أو الإغماء.
- الشعور بألم شديد في العضلات.
- التحدُّث بشكل غير مفهوم.
يحتاج علاج المصاب ببكتيريا الدم إلى البقاء في المستشفى طوال فترة العلاج، حيث إنَّه من الممكن أن تُؤثِّر في عمل أعضاء الجسم المختلفة، ويبدأ العلاج باستخدام مُضادٍّ حيويّ قويّ يستطيع القضاء على نوعي البكتيريا الموجبة والسالبة، حيث لا يُوجَد وقت لتحديد نوع البكتيريا المُسبِّبة لتجرثم الدم، وبعد معرفة نوع البكتيريا المُسبِّبة لتجرثم الدم يتمّ إعطاء مُضادٍّ حيويّ خاصّ بها، وفي الغالب يتمّ إعطاء الأدوية والسوائل عن طريق الوريد؛ للمحافظة على ضغط الدم، ومنع حدوث التخثُّرات، وقد يتمّ استخدام قناع الأكسجين في حال وجود مشاكل في التنفُّس، ويعتمد علاج المريض على عِدَّة عوامل، ومنها ما يأتي:[٣]
- المقدرة على تحمُّل الأدوية.
- العمر.
- الصحَّة العامَّة للمريض.
- مدى حالة المريض.
قد تُؤدِّي الإصابة بأيّة عدوى إلى الإصابة ببكتيريا الدم، إلا أنَّ هناك بعض العوامل التي تزيد من فرصة الإصابة ببكتيريا الدم، مثل:[٤]
- الأمراض المزمنة، مثل: داء السكَّري، وأمراض الكلى، والرئتَين.
- إجراء عمليّة جراحيّة حديثاً، أو زراعة أعضاء.
- التعرُّض لحروق شديدة.
- العمر أقل من سنة، وأكبر من 65 سنة.
- ضعف جهاز المناعة.
- الالتهاب الرئويّ من أكثر الالتهابات المُسبِّبة لتجرثم الدم، يليه التهاب المسالك البوليّة، والتهابات الجهاز الهضميّ، والالتهابات الجلديّة.
- ↑ “What is Sepsis?”, www.webmd.com, Retrieved 12-4-2019. Edited.
- ^ أ ب “Septicemia: Know the facts”, www.medicalnewstoday.com, Retrieved 12-4-2019. Edited.
- ↑ “Septicemia”, www.healthline.com, Retrieved 14-4-2019. Edited.
- ↑ “Septicemia: Know the facts”, www.medicalnewstoday.com, Retrieved 14-4-2019. Edited.